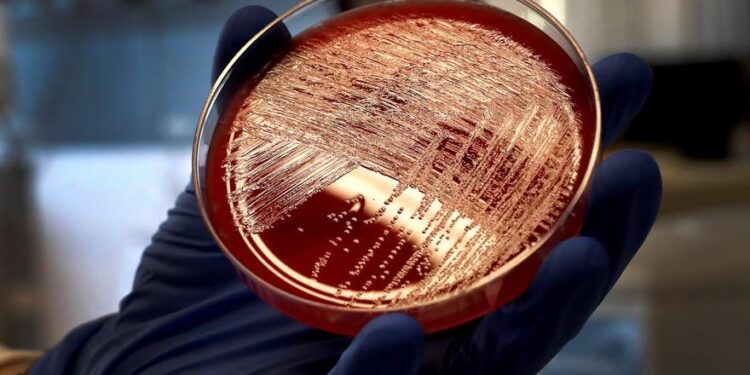
Doi minori mor la Madrid și alți 14 sunt tratați pentru streptococ A

Comunitatea Madrid a depistat, din 19 octombrie trecut, 16 cazuri de minori cu boală invazivă din cauza streptococul Ainclusiv doi pacienți decedați, iar în acest moment, după alerta emisă de Regatul Unit, se studiază dacă frecvența acestor infecții este mai mare decât de obicei.
Continua să citești….
Sursa: www.epe.es